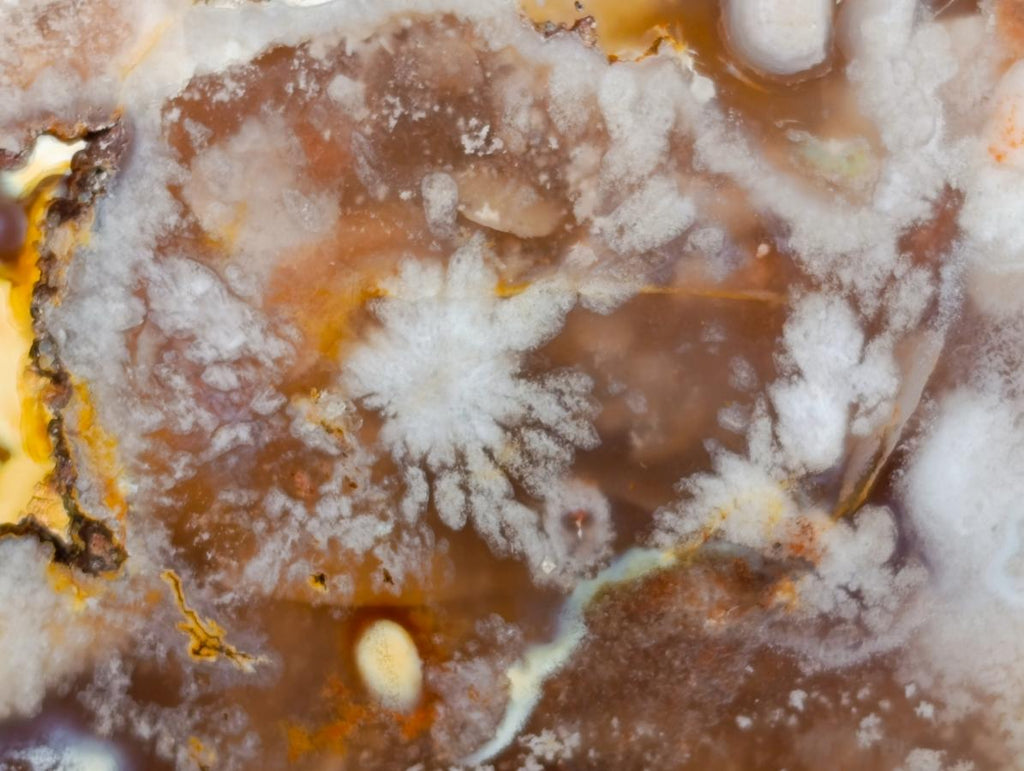
Polished Flower Agate Standing Free Forms x 2 From Antsahalova, Madagascar
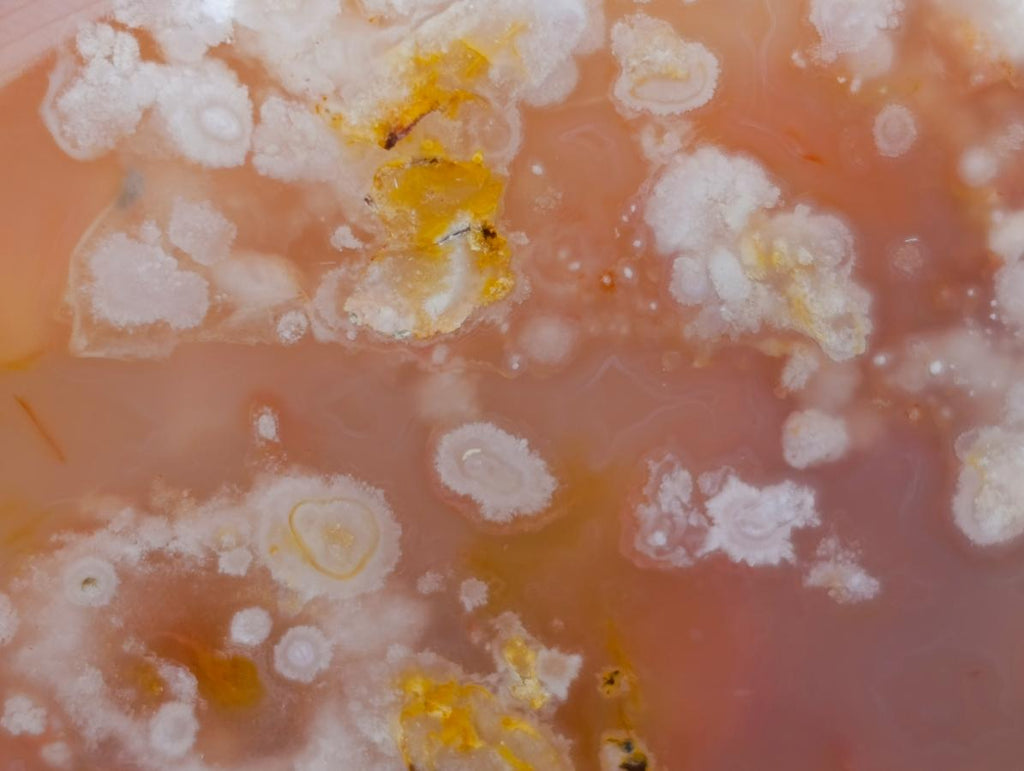
Polished Flower Agate Standing Free Forms x 2 From Antsahalova, Madagascar
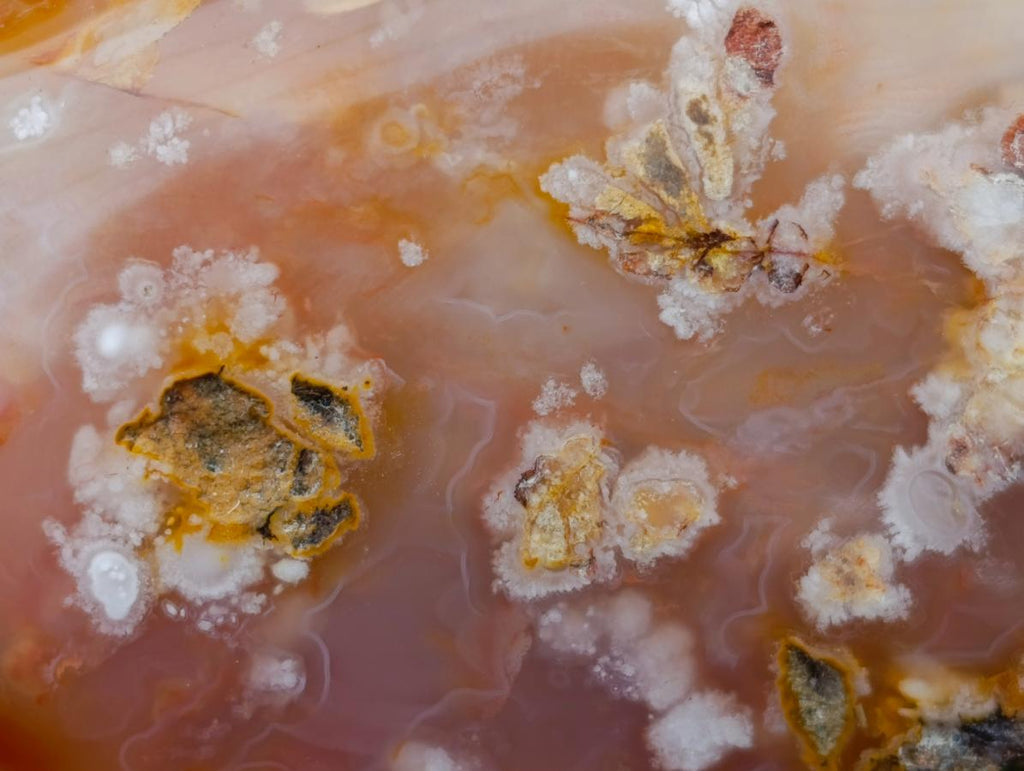
Polished Flower Agate Standing Free Forms x 2 From Antsahalova, Madagascar

Welcome to TOPROCKS.COM - You are shopping on our RETAIL site for worldwide customers and collectors. You are welcome to Shop and Ship any of our 20,000+ specimens with no minimum requirements. For WHOLESALE access, please Login using your 'Approved Wholesale / Trade' email address (HOW?) or email Renate@Toprocks.com

Polished Flower Agate Standing Free Forms x 2 From Antsahalova, Madagascar
RETAIL PRICE
A NOTE FROM NICK
A Pair of A Grade Polished Coral Flower Agate Standing Display Pieces with Calcified Polyps in Clear Orange Chalcedony.
PRODUCT DESCRIPTION
A Contemporary Gemological Marvel
Flower Agate from Madagascar is a Chalcedony based fossil coral pseudomorphic Agate type that displays intricate floral-like frozen Polyp inclusions. This unique stone showcases soft hues of pink, peach, and beige in translucent Chalcedony, capturing the natural beauty of ancient fossils that have been preserved from volcanic spew over into the ocean, filling up the reefs and permeating their forms with Silica from the Basalt lava and forming into Chalcedony and Agate over millennia.
PRODUCT MINERALS
Silica, Chalcedony, Coral
PRODUCT FEATURES
Floral Formations, Fossil, Pseudomorph, Translucent
PRODUCT COLOUR
Red, White, Yellow, Pink, Beige
MOHS HARDNESS SCALE
6.5 - 7
PRODUCT DATA
Locality = Antsahalova, Madagascar
Grade = A Grade
Size = 87 - 94 mm